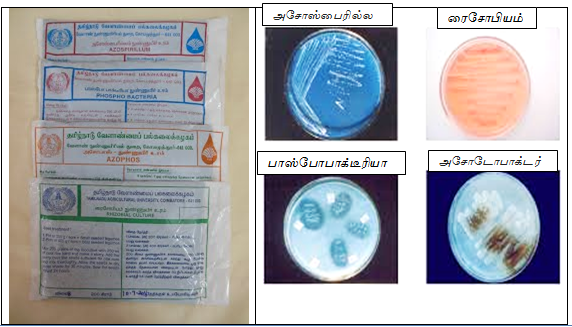

மல்பெரியில் உயிர் உர மேலாண்மை
பட்டு உற்பத்தியில் மல்பெரி இலை முக்கிய பங்கு வகிக்கிறது. மல்பெரி செடிகளை பயிரிட்டு அதன் இலைகளை பட்டுப்புழுக்களுக்கு உணவாக கொடுக்கின்றனர். இந்தியா பட்டு உற்பத்தியில் இரண்டாம் இடம் வகிக்கிறது. பட்டுப்புழுவின் வளர்ச்சி மற்றும் பட்டுக்கூடு விளைச்சல், மல்பெரி இலைகளின் தரத்தைச் சார்ந்து இருக்கிறது. உயிர் உரங்கள் இடுவதன் மூலம்…